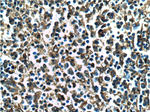
Annexin V Antibody in Immunohistochemistry (Paraffin) (IHC (P))

Search
Proteintech
Annexin V Monoclonal Antibody (1E6A8)
{{$productOrderCtrl.translations['antibody.pdp.commerceCard.promotion.promotions']}}
{{$productOrderCtrl.translations['antibody.pdp.commerceCard.promotion.viewpromo']}}
{{$productOrderCtrl.translations['antibody.pdp.commerceCard.promotion.promocode']}}: {{promo.promoCode}} {{promo.promoTitle}} {{promo.promoDescription}}. {{$productOrderCtrl.translations['antibody.pdp.commerceCard.promotion.learnmore']}}
产品信息
66245-1-IG
种属反应
宿主/亚型
分类
类型
克隆号
抗原
偶联物
形式
浓度
规格
纯化类型
保存液
内含物
保存条件
运输条件
产品详细信息
Immunogen sequence: MAQVLRGTV TDFPGFDERA DAETLRKAMK GLGTDEESIL TLLTSRSNAQ RQEISAAFKT LFGRDLLDDL KSELTGKFEK LIVALMKPSR LYDAYELKHA LKGAGTNEKV LTEIIASRTP EELRAIKQVY EEEYGSSLED DVVGDTSGYY QRMLVVLLQA NRDPDAGIDE AQVEQDAQAL FQAGELKWGT DEEKFITIFG TRSVSHLRKV FDKYMTISGF QIEETIDRET SGNLEQLLLA VVKSIRSIPA YLAETLYYAM KGAGTDDHTL IRVMVSRSEI DLFNIRKEFR KNFATSLYSM IKGDTSGDYK KALLLLCGED D (1-320 aa encoded by BC001429)
靶标信息
The protein encoded by this gene belongs to the annexin family of calcium-dependent phospholipid binding proteins some of which have been implicated in membrane-related events along exocytotic and endocytotic pathways. Annexin 5 is a phospholipase A2 and protein kinase C inhibitory protein with calcium channel activity and a potential role in cellular signal transduction, inflammation, growth and differentiation. Annexin 5 has also been described as placental anticoagulant protein I, vascular anticoagulant-alpha, endonexin II, lipocortin V, placental protein 4 and anchorin CII. The gene spans 29 kb containing 13 exons, and encodes a single transcript of approximately 1.6 kb and a protein product with a molecular weight of about 35 kDa.
仅用于科研。不用于诊断过程。未经明确授权不得转售。
篇参考文献 (0)
生物信息学
蛋白别名: Anchorin CII; Annexin A5; Annexin V; Annexin-5; anticoagulant precursor (5' end put.); putative; ANXA5; Calphobindin I; CBP-I; CPB-I; Endonexin II; epididymis secretory protein Li 7; Lipocortin V; lipocortin-V; PAP-I; Placental anticoagulant protein 4; Placental anticoagulant protein I; PP4; Thromboplastin inhibitor; unnamed protein product; VAC-alpha; Vascular anticoagulant-alpha
基因别名: ANX5; ANXA5; CPB-I; ENX2; HEL-S-7; PP4; R74653; RPRGL3; VAC-alph
UniProt ID: (Human) P08758, (Mouse) P48036
Entrez Gene ID: (Human) 308, (Mouse) 11747